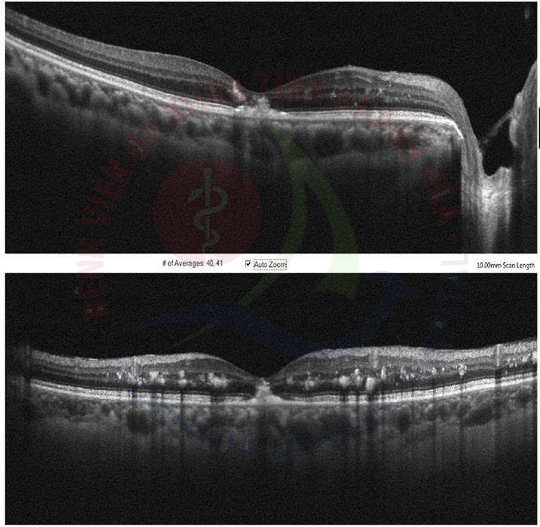

Bạn có biết, bệnh võng mạc đái tháo đường là một trong những biến chứng nguy hiểm của bệnh tiểu đường, ảnh hưởng trực tiếp đến đôi mắt? Bệnh xảy ra do các mạch máu tại võng mạc bị tổn thương.
Ở giai đoạn đầu, bệnh thường tiến triển âm thầm, có thể không có triệu chứng rõ rệt hoặc chỉ làm thị lực suy giảm nhẹ. Tuy nhiên, nếu không được phát hiện và điều trị kịp thời, bệnh có thể dẫn đến mất thị lực vĩnh viễn (mù lòa).
1. Ai có nguy cơ cao mắc bệnh võng mạc đái tháo đường?
Bất kỳ ai mắc bệnh đái tháo đường (tuýp 1, tuýp 2 hay đái tháo đường thai kỳ) đều có nguy cơ. Nguy cơ này sẽ càng cao hơn nếu bạn có các yếu tố sau:
🗓️ Thời gian mắc bệnh tiểu đường càng lâu
📈 Đường huyết không được kiểm soát tốt, thường xuyên ở mức cao
🩸 Huyết áp cao
🧈 Cholesterol cao
2. Tầm soát bệnh lý võng mạc đái tháo đường như thế nào? 🔬
Ngay khi được chẩn đoán mắc bệnh đái tháo đường, người bệnh cần đi khám mắt chuyên sâu để tầm soát sớm. Tại Bệnh viện, bạn sẽ được thăm khám qua các bước:
✅ Đo thị lực để đánh giá chức năng nhìn.
✅ Khám tổng quát về mắt bằng đèn sinh hiển vi.
✅ Soi đáy mắt: Bác sĩ sẽ nhỏ thuốc để làm giãn đồng tử, giúp quan sát rõ bên trong đáy mắt, phát hiện các tổn thương sớm nhất.
✅ Chụp hình màu đáy mắt và chụp cắt lớp quang học (OCT): Khi có nghi ngờ tổn thương, các phương pháp này giúp đánh giá chi tiết tình trạng phù hoàng điểm và tổn thương võng mạc.
✅ Chụp mạch máu OCT (OCT-A): Đây là một kỹ thuật hiện đại, không xâm lấn, cho phép bác sĩ quan sát chi tiết hệ thống mạch máu ở võng mạc mà người bệnh không cần tiêm thuốc cản quang như phương pháp cũ.
3. Điều trị bằng tiêm thuốc nội nhãn Anti-VEGF: Phương pháp hiện đại và hiệu quả ✨
Tiêm thuốc nội nhãn Anti-VEGF là một trong những phương pháp tiên tiến và hiệu quả hàng đầu hiện nay để điều trị bệnh võng mạc đái tháo đường.
Đây là một thủ thuật nhanh chóng, bác sĩ sẽ đưa một lượng thuốc rất nhỏ vào bên trong nhãn cầu. Ưu điểm lớn của phương pháp này là thuốc tác động trực tiếp tại mắt, giúp đạt nồng độ tối ưu và hạn chế tối đa tác dụng phụ toàn thân. Việc tiêm thuốc giúp giảm phù hoàng điểm, cải thiện thị lực và làm chậm quá trình suy giảm thị lực.
Một liệu trình điều trị có thể bao gồm nhiều mũi tiêm, mỗi mũi cách nhau khoảng 1 tháng. Các loại thuốc thường dùng gồm: Avastin, Eylea, Lucentis…
🏥 Tại khoa Mắt – Bệnh viện Đa khoa Khánh Hòa, chúng tôi đang áp dụng hiệu quả phương pháp này với thuốc Avastin, giúp nhiều người bệnh bảo vệ thị lực.
4. Làm sao để phòng ngừa biến chứng ở mắt do đái tháo đường? ✅
“Phòng bệnh hơn chữa bệnh!” Để bảo vệ đôi mắt sáng khỏe, người bệnh tiểu đường hãy:
👍 Chủ động kiểm soát đường huyết: Giữ đường huyết ở mức ổn định là “chìa khóa” để bảo vệ mạch máu.
👍 Tuân thủ lịch khám mắt định kỳ: Khám mắt thường xuyên (3-6 tháng/lần hoặc theo chỉ định của bác sĩ) giúp phát hiện sớm và điều trị kịp thời.
👍 Giữ huyết áp và cholesterol ở mức an toàn.
👍 Nói không với thuốc lá: Hút thuốc lá làm tăng nguy cơ mắc các biến chứng của tiểu đường, bao gồm cả bệnh võng mạc.
TÓM TẮT DÀNH CHO BẠN:
Nguy cơ: Bệnh võng mạc tiểu đường có thể gây mù lòa vĩnh viễn.
Hành động: Người bệnh tiểu đường CẦN khám mắt định kỳ ngay cả khi chưa thấy triệu chứng.
Giải pháp: Đã có phương pháp tiêm nội nhãn hiện đại, hiệu quả (đang áp dụng tại Bệnh viện Đa khoa Khánh Hòa).
Phòng ngừa: Kiểm soát tốt đường huyết, huyết áp, cholesterol và không hút thuốc là cách tốt nhất để bảo vệ đôi mắt.

BS. Bùi Quỳnh Phương – Khoa Mắt








